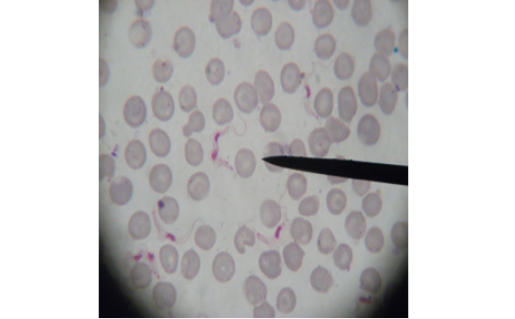

The Journal of Advances in Parasitology
Showing long slender form of T. evansi in examined camel (x 1000).
Showing intermediate form of T. evansi in examined camel (x 1000).
Showing short stumpy form of T. evansi in examined camel (x 1000).
Showing divisional features of T. evansi i.e.; presence of two kinetoplast in examined camel (x 1000).
Showing two nuclei of T. evansi in examined camel (x 1000).
Showing two flagella of T. evansi in examined camel (x 1000).
Showing uncommon shape alterations were documented; sphaeromastigote of T. evansi in examined camel (x 1000).
Showing amastigote form of T. evansi in examined camel (x 1000).
Showing dyskinetoplastic form of T. evansi in examined camel (x 1000).
The mean of parasitemia of Tyrpanosoma evansi in all passages.
Showing slender form of T. evansi in blood of infected mouse and divisional stage characterized by presence of two kinetoplast and two nuclei. x1000.